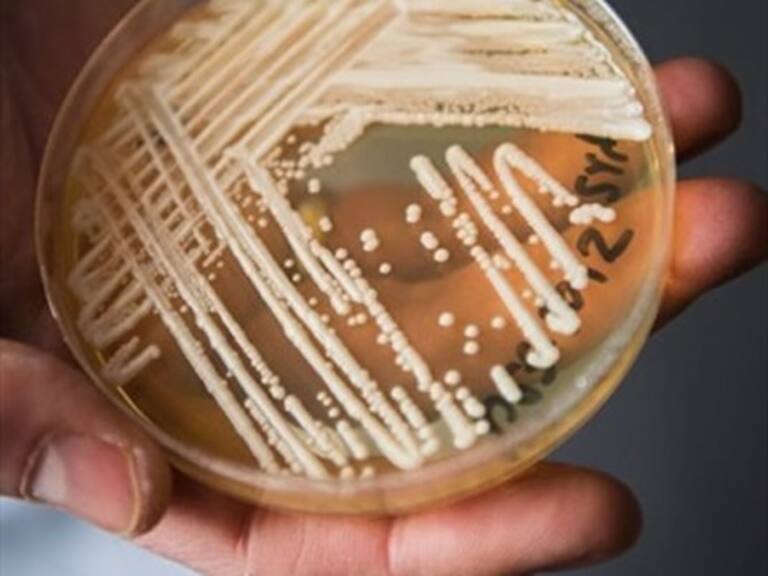
Confirman primer caso en Chile de paciente con hongo Candida auris

Confirman primer caso en Chile de paciente con hongo Candida auris
El hallazgo se dio tras una serie de exámenes en una persona con diagnóstico previo de diabetes.
La Sociedad Chilena de Infectología (Sochinf), confirmó que se registró el primer caso de un paciente contagiado con el Candida Auris, el peligroso hongo que afecta al torrente sanguíneo, el sistema respiratorio, la orina y heridas previas en pacientes hospitalizados que cuentan con el sistema inmune debilitado.
Según reportó la entidad, se trata de un paciente indio, quien lleva radicado en Chile 30 años y que fue trasladado durante agosto de 2018 a Bombay, a raíz de un diagnóstico previo de diabetes. Sin embargo, a una semana de volver al país, en octubre del mismo año, tuvo síntomas compatibles con una necrosis en la falange distal tercer ortejo psilateral, por lo que en su retorno consultó en el Servicio de Urgencia de un centro privado.
Tras esto, fue derivado al Hospital de Salvador, en donde se le practicaron varios exámenes, los cuales arrojaron que en una de sus heridas estaba alojado el peligroso hongo.
El Candida auris fue descubierto hace una década en Corea del Sur y ha tenido una rápida propagación en diversos países del mundo; contando además con un factor clave como lo es el ser inmune a los medicamentos.
Sigue a ADN.cl en Google Discover
Recibe nuestros contenidos directamente en tu feed.






















